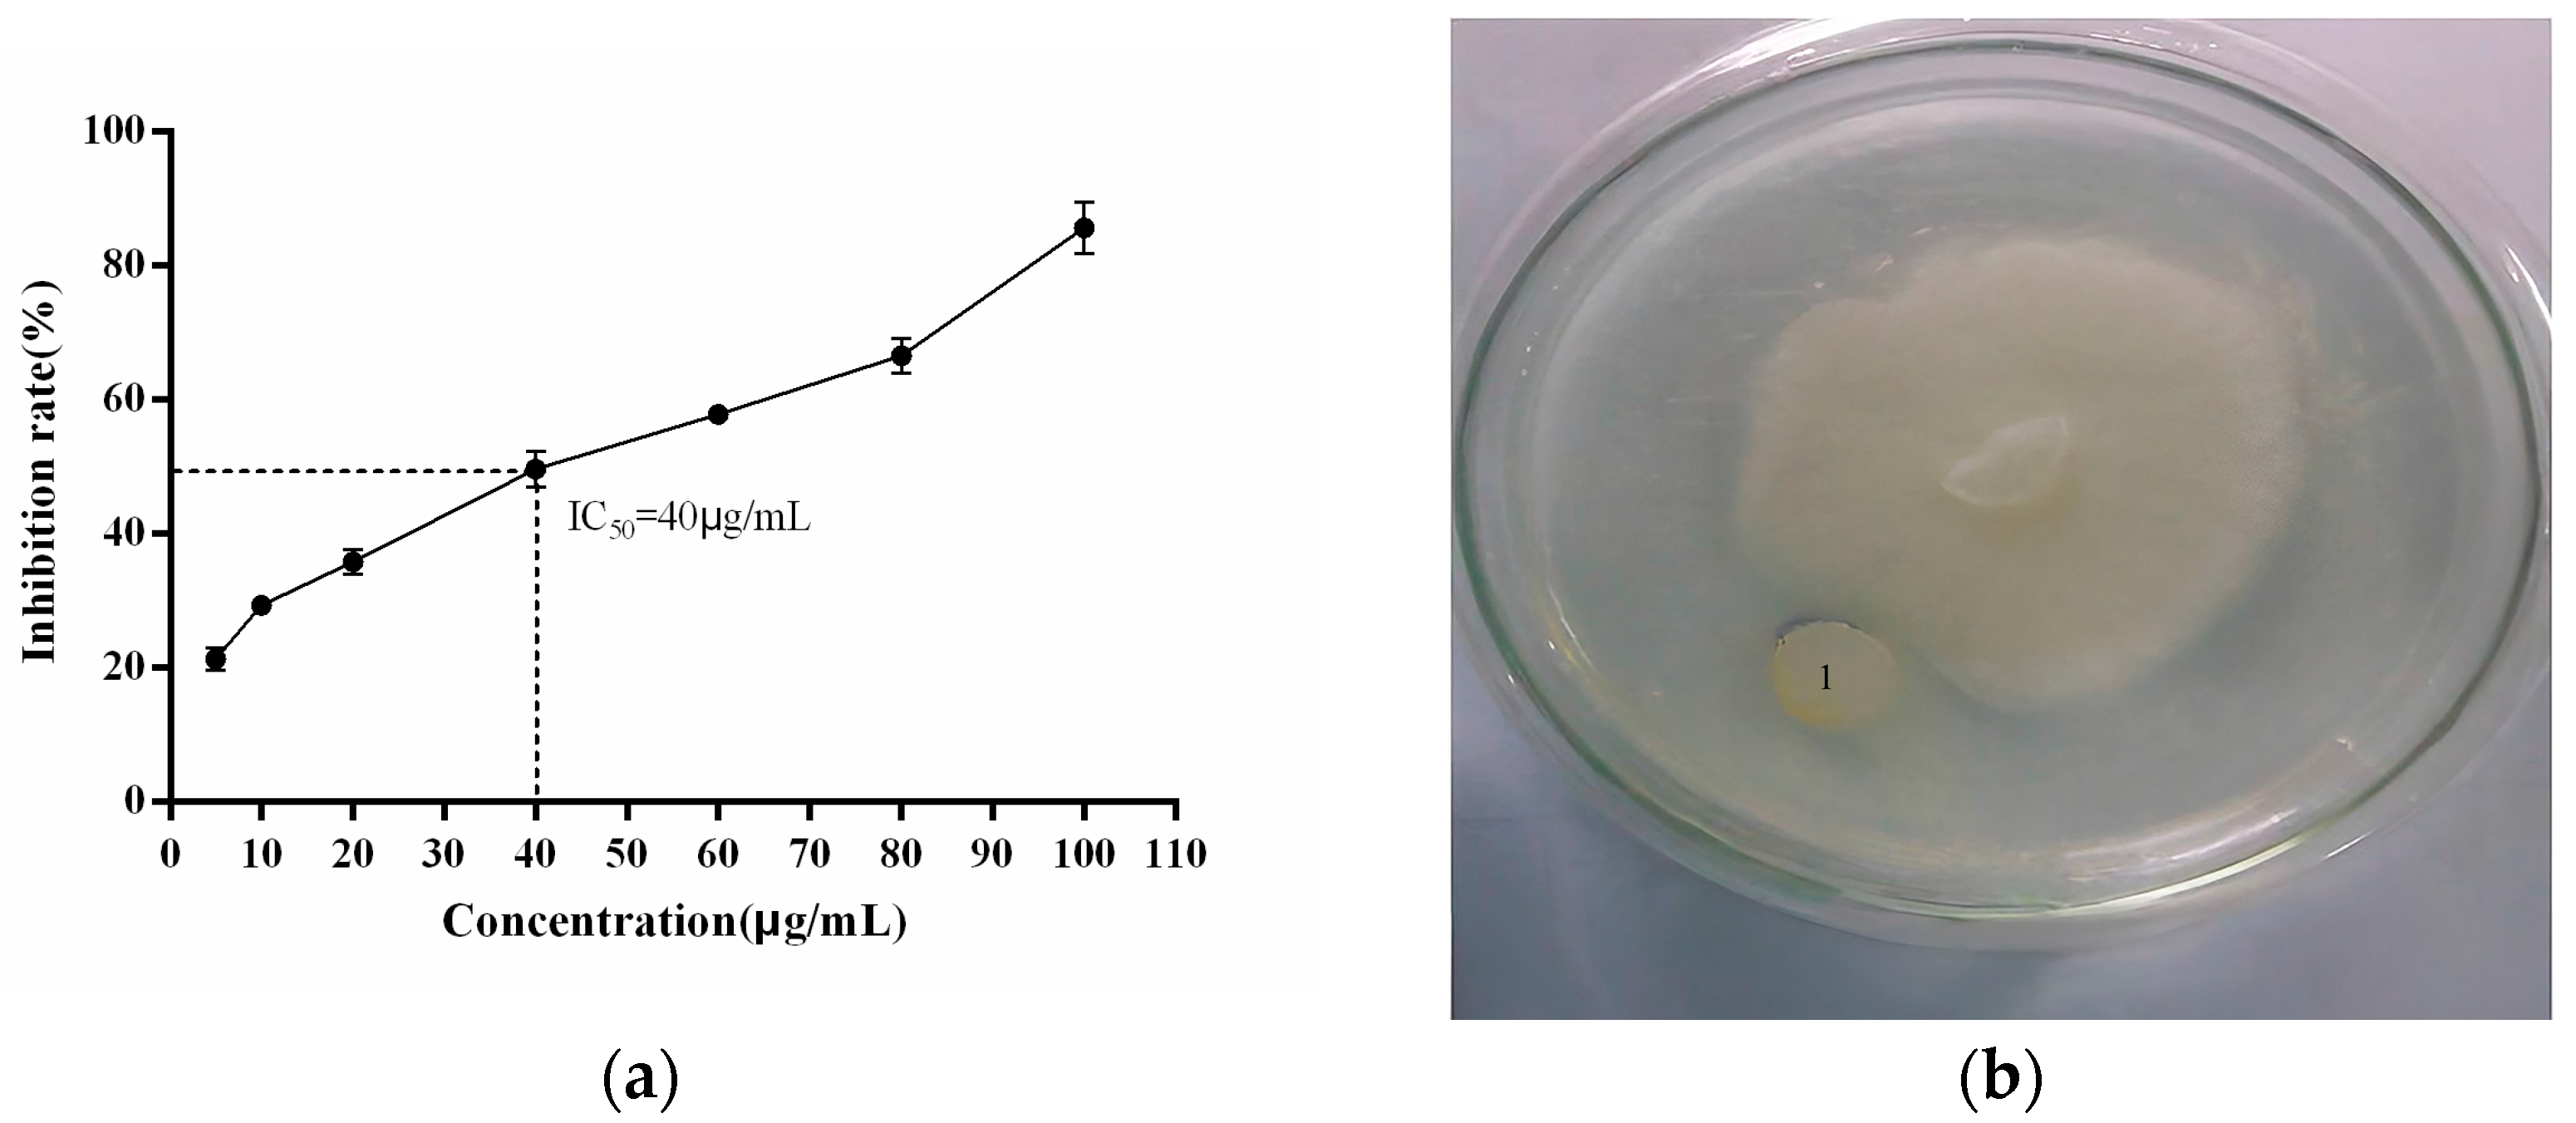
Plants 13 02731 g011

Bioinformatics Analysis of the Panax ginseng Cyclophilin Gene and Its Anti-Phytophthora cactorum Activity
Abstract
1. Introduction
2. Results
2.1. Cloning and Sequencing of the PgCyP Gene
2.2. Results of the Bioinformatics Analysis
2.2.1. Analysis of Amino Acid Residues
2.2.2. Analysis of the Hydrophobicity/Hydrophilicity of the PgCyP Protein
2.2.3. Analysis of the Advanced Structure of the PgCyP Protein
2.2.4. Analysis of the Cis-Acting Element of the Promoter of the PgCyP Gene
2.2.5. Prediction of Signal Peptides and the Transmembrane Structure
2.2.6. Analysis of the Phylogenetic Tree of the PgCyP Protein
2.2.7. Prediction Results of the Phosphorylation Sites of the PgCyP Protein
2.3. Anti-P. cactorum Activity of the Recombinant PgCyP Protein
2.3.1. Effect of the Recombinant PgCyP Protein on the Spores
2.3.2. Effect of the Recombinant PgCyP Protein on the P. cactorum Resistance
3. Discussion
4. Materials and Methods
4.1. Materials
4.2. Reagents and Instruments
4.3. Obtaining and Cloning of the PgCyP Gene
4.4. Bioinformatics Analysis
4.5. Expression and Purification of PgCyP
4.6. Preparation of the Spore Suspension
4.7. Experimentation on the Anti-Phytophthora cactorum Activity of the Recombinant Protein
4.7.1. Effects of Different Concentrations of PgCyP on P. cactorum
4.7.2. P. cactorum Activity Inhibition
4.7.3. Effect of the Recombinant Protein on Spores
4.7.4. Effect of the Recombinant Protein on the P. cactorum Resistance of A. thaliana
4.8. Statistical Analysis
5. Conclusions
Author Contributions
Funding
Data Availability Statement
Acknowledgments
Conflicts of Interest
References
- Zhou, J.M.; Zhang, Y. Plant immunity: Danger perception and signaling. Cell 2020, 181, 978–989. [Google Scholar] [CrossRef] [PubMed]
- Yuan, M.; Ngou, B.P.; Ding, P.; Xin, X.F. PTI-ETI crosstalk: An integrative view of plant immunity. Curr. Opin. Plant Biol. 2021, 62, 102030. [Google Scholar] [CrossRef] [PubMed]
- Cui, H.; Tsuda, K.; Parker, J.E. Effector-triggered immunity: From pathogen perception to robust defense. Ann. Rev. Plant Biol. 2015, 66, 487–511. [Google Scholar] [CrossRef]
- Couto, D.; Zipfel, C. Regulation of pattern recognition receptor signalling in plants. Nat. Rev. Immunol. 2016, 16, 537–552. [Google Scholar] [CrossRef] [PubMed]
- Peng, Y.; van Wersch, R.; Zhang, Y. Convergent and divergent signaling in PAMP-triggered immunity and effector-triggered immunity. Mol. Plant Microbe Interact. 2018, 31, 403–409. [Google Scholar] [CrossRef] [PubMed]
- Thulasi Devendrakumar, K.; Li, X.; Zhang, Y. MAP kinase signalling: Interplays between plant PAMP-and effector-triggered immunity. Cell Mol. life Sci. 2018, 75, 2981–2989. [Google Scholar] [CrossRef] [PubMed]
- Yuan, M.; Jiang, Z.; Bi, G.; Nomura, K.; Liu, M.; Wang, Y.; Cai, B.; Zhou, J.M.; He, S.Y.; Xin, X.F. Pattern-recognition receptors are required for NLR-mediated plant immunity. Nature 2021, 592, 105–109. [Google Scholar] [CrossRef] [PubMed]
- Ali, S.; Ganai, B.A.; Kamili, A.N.; Bhat, A.A.; Mir, Z.A.; Bhat, J.A.; Tyagi, A.; Islam, S.T.; Mushtaq, M.; Yadav, P.; et al. Pathogenesis-related proteins and peptides as promising tools for engineering plants with multiple stress tolerance. Microbio Res. 2018, 213, 29–37. [Google Scholar] [CrossRef]
- Vitali, A.; Pacini, L.; Bordi, E.; De Mori, P.; Pucillo, L.; Maras, B.; Botta, B.; Brancaccio, A.; Giardina, B. Purification and characterization of an antifungal thaumatin-like protein from cassia didymobotrya cell culture. Plant Physiol. Biochem. 2006, 44, 604–610. [Google Scholar] [CrossRef]
- Vijayan, S.; Guruprasad, L.; Kirti, P.B. Prokaryotic expression of a constitutively expressed Tephrosia villosa defensin and its potent antifungal activity. Appl. Microbiol. Biotechnol. 2008, 80, 1023–1032. [Google Scholar] [CrossRef]
- Holaskova, E.; Galuszka, P.; Frebort, I.; Tufan, M.O. Antimicrobial peptide production and plant-based expression systems for medical and agricultural biotechnology. Biotechnol. Adv. 2015, 33, 1005–1023. [Google Scholar] [CrossRef] [PubMed]
- Galat, A. Variations of sequences and amino acid compositions of proteins that sustain their biological functions: An analysis of the cyclophilin family of proteins. Arch. Biochem. Biophys. 1999, 371, 149–162. [Google Scholar] [CrossRef] [PubMed]
- Meza-Zepeda, L.A.; Baudo, M.M.; Palva, E.T.; Heino, P. Isolation and characterization of a cDNA corresponding to a stress-activated cyclophilin gene in Solanum commersonii. J. Exp. Bot. 1998, 49, 1451–1452. [Google Scholar] [CrossRef]
- Gogoi, A.; Lysøe, E.; Eikemo, H.; Stensvand, A.; Davik, J.; Brurberg, M.B. Comparative Transcriptome Analysis Reveals Novel Candidate Resistance Genes Involved in Defence against Phytophthora cactorum in Strawberry. Int. J. Mol. Sci. 2023, 24, 10851. [Google Scholar] [CrossRef]
- Marin, M.V.; Baggio, J.S.; Oh, Y.; Han, H.; Chandra, S.; Wang, N.Y.; Lee, S.; Peres, N.A. Identification of sequence mutations in Phytophthora cactorum genome associated with mefenoxam resistance and development of a molecular assay for the mutant detection in strawberry (F.× ananassa). Sci. Rep. 2023, 13, 7385. [Google Scholar] [CrossRef]
- Pathak, V.M.; Verma, V.K.; Rawat, B.S.; Kaur, B.; Babu, N.; Sharma, A.; Dewali, S.; Yadav, M.; Kumari, R.; Singh, S.; et al. Current status of pesticide effects on environment, human health and it’s eco-friendly management as bioremediation: A comprehensive review. Front. Microbiol. 2022, 13, 962619. [Google Scholar] [CrossRef] [PubMed]
- Rajmohan, K.S.; Chandrasekaran, R.; Varjani, S. A review on occurrence of pesticides in environment and current technologies for their remediation and management. Indian. J. Microbiol. 2020, 60, 125–138. [Google Scholar] [CrossRef]
- Ye, X.Y.; Ng, T.B. Isolation of unguilin, a cyclophilin-like protein with anti-mitogenic, antiviral, and antifungal activities, from black-eyed pea. J. Protein Chem. 2001, 20, 353–359. [Google Scholar] [CrossRef] [PubMed]
- Ruan, S.L.; Ma, H.S.; Wang, S.H.; Fu, Y.P.; Xin, Y.; Liu, W.Z.; Wang, F.; Tong, J.X.; Wang, S.Z.; Chen, H.Z. Proteomic identification of OsCYP2, a rice cyclophilin that confers salt tolerance in rice (Oryza sativa L.) seedlings when overexpressed. BMC Plant Bio 2011, 11, 34. [Google Scholar] [CrossRef]
- Lee, J.R.; Park, S.C.; Kim, J.Y.; Lee, S.S.; Park, Y.; Cheong, G.W.; Hahm, K.S.; Lee, S.Y. Molecular and functional characterization of a cyclophilin with antifungal activity from chinese cabbage. Biochem. Biophys. Res. Commun. 2007, 553, 672–678. [Google Scholar] [CrossRef]
- Jackson, K.; Söll, D. Mutations in a new Arabidopsis cyclophilin disrupt its interaction with protein phosphatase 2a. Mol. Gen. Genet. 1999, 262, 830–838. [Google Scholar] [CrossRef] [PubMed]
- Liu, Y.X.; Wu, C.H. Research on ginseng diseases in Korea. J. Ginseng Res. 1993, 17, 61–68. [Google Scholar]
- Lee, B.D.; Dutta, S.; Ryu, H.; Yoo, S.J.; Suh, D.S.; Park, K. Induction of systemic resistance in Panax ginseng against Phytophthora cactorum by native bacillus amyloliquefaciens hk34. J. Ginseng Res. 2015, 39, 213–220. [Google Scholar] [CrossRef] [PubMed]
- Liu, J.; Wang, Q.; Sun, M.; Zhu, L.; Yang, M.; Zhao, Y. Selection of reference genes for quantitative real-time PCR normalization in Panax ginseng at different stages of growth and in different organs. PLoS ONE 2014, 9, e112177. [Google Scholar] [CrossRef]
- Gasteiger, E.; Hoogland, C.; Gattiker, A.; Duvaud, S.E.; Wilkins, M.R.; Appel, R.D.; Bairoch, A. Protein Identification and Analysis Tools on the ExPASy Server. In The Proteomics Protocols Handbook; Walker, J.M., Ed.; Humana Press: Humana Totowa, NJ, USA, 2005; pp. 571–607. [Google Scholar] [CrossRef]
- Kelley, L.A.; Mezulis, S.; Yates, C.M.; Wass, M.N.; Sternberg, M.J. The phyre2 web portal for protein modeling, prediction and analysis. Nat. Protoc. 2015, 10, 845–858. [Google Scholar] [CrossRef]
- Luan, X.; Yang, W.; Bai, X.; Li, H.; Li, H.; Fan, W.; Zhang, H.; Liu, W.; Sun, L. Cyclophilin A is a key positive and negative feedback regulator within interleukin-6 trans-signaling pathway. FASEB J. 2021, 35, e21958. [Google Scholar] [CrossRef] [PubMed]
- Zhou, S.; Yu, Q.; Zhang, L.; Jiang, Z. Cyclophilin D-mediated Mitochondrial Permeability Transition Regulates Mitochondrial Function. Curr. Pharm. Des. 2023, 29, 620–629. [Google Scholar] [CrossRef]
- Fischer, G.; Wittmann-Liebold, B.; Lang, K.; Kiefhaber, T.; Schmid, F.X. Cyclophilin and peptidyl-prolyl cis-trans isomerase are probably identical proteins. Nature 1989, 337, 476–478. [Google Scholar] [CrossRef] [PubMed]
- Duina, A.A.; Chang, H.C.; Marsh, J.A.; Lindquist, S.; Gaber, R.F. A cyclophilin function in Hsp90-dependent signal transduction. Science 1996, 274, 1713–1715. [Google Scholar] [CrossRef]
- Takahashi, N.; Hayano, T.; Suzuki, M. Peptidyl-prolyl cis-trans isomerase is the cyclosporin A-binding protein cyclophilin. Nature 1989, 337, 473–475. [Google Scholar] [CrossRef]
- Marivet, J.; Margis-Pinheiro, M.; Frendo, P.; Burkard, G. Bean cyclophilin gene expression during plant development and stress conditions. Plant Mol. Biol. 1994, 26, 1181–1189. [Google Scholar] [CrossRef] [PubMed]
- Nielsen, H.; Tsirigos, K.D.; Brunak, S.; Heijne, G.V. A brief history of protein sorting prediction. Protein J. 2019, 38, 200–216. [Google Scholar] [CrossRef] [PubMed]
- Sonnhammer, E.L.; Heijne, G.V.; Krogh, A. A hidden Markov model for predicting transmembrane helices in protein sequences. Proc. Int. Conf. Intell. Syst. Mol. Biol. 1998, 6, 175–182. [Google Scholar] [PubMed]
- Zhang, H.; Wang, J.; Li, S.; Wang, S.; Liu, M.; Wang, W.; Zhao, Y. Molecular cloning, expression, purification and functional characterization of an antifungal cyclophilin protein from Panax ginseng. Biomed Rep. 2017, 7, 527–531. [Google Scholar] [CrossRef] [PubMed]
- Seo, H.H.; Park, S.; Park, S.; Oh, B.J.; Back, K.; Han, O.; Kim, J.I.; Kim, Y.S. Overexpression of a defensin enhances resistance to a fruit-specific anthracnose fungus in pepper. PLoS ONE 2014, 9, e97936. [Google Scholar] [CrossRef] [PubMed]
- Karri, V.; Bharadwaja, K.P. Tandem combination of trigonella foenum-graecum defensin (Tfgd2) and raphanus sativus antifungal protein (RsAFP2) generates a more potent antifungal protein. Funct. Integr. Genom. 2013, 13, 435–443. [Google Scholar] [CrossRef] [PubMed]
- Xiao, S.; Chye, M.L. Overexpression of Arabidopsis ACBP3 enhances NPR1-dependent plant resistance to Pseudomonas syringe pv tomato DC3000. Plant Physiol. 2011, 156, 2069–2081. [Google Scholar] [CrossRef]

| Element | Type | Function | Sequence | No. |
|---|---|---|---|---|
| ABRE | Hormone regulatory element | ABA-responsive cis-acting element | ACGTG | 1 |
| CAAT-box | Upstream elements of the genome | Gene regulatory region | CAAAT | 2 |
| CAAT-box | Upstream elements of the genome | Gene regulatory region | CAAT | 1 |
| G-Box | Light regulatory element | Light response relative cis-acting element | CACGTT | 1 |
| G-box | Light regulatory element | Light response relative cis-acting element | TAACACGTAG | 1 |
| LTR | Stress inducing element | Low-temperature response relative cis-acting element | CCGAAA | 1 |
| TATA-box | Upstream elements of the genome | Core promoter element | ATATAT | 1 |
| TATA-box | Upstream elements of the genome | Core promoter element | ATATAA | 1 |
| TATA-box | Upstream elements of the genome | Core promoter element | TATA | 2 |
| Gene | Accession Numbers | Primers’ Sequence (5’–3’) |
|---|---|---|
| CyP | ANA12002.1 | F: CGGATCCATGGCCAACCCAA |
| R: ATTTGCGGCCGCGTGGTGGTGGTGGTGGTGCTCGAG | ||
| V-ATP | KF699328 | F: AAGAGTGCCATTGGTGAGG |
| R: CCTTGAGCGACAAACTTCC | ||
| CyP | KF699321 | F: CAGGCAAAGAAAAAGTCAAGTG |
| R: AAAGAGACCCATTACAATACGC |
Disclaimer/Publisher’s Note: The statements, opinions and data contained in all publications are solely those of the individual author(s) and contributor(s) and not of MDPI and/or the editor(s). MDPI and/or the editor(s) disclaim responsibility for any injury to people or property resulting from any ideas, methods, instructions or products referred to in the content. |
© 2024 by the authors. Licensee MDPI, Basel, Switzerland. This article is an open access article distributed under the terms and conditions of the Creative Commons Attribution (CC BY) license (https://creativecommons.org/licenses/by/4.0/).
Share and Cite
Zhao, Y.; Lu, J.; Wang, Y.; Hao, K.; Liu, Z.; Hui, G.; Sun, T. Bioinformatics Analysis of the Panax ginseng Cyclophilin Gene and Its Anti-Phytophthora cactorum Activity. Plants 2024, 13, 2731. https://doi.org/10.3390/plants13192731
Zhao Y, Lu J, Wang Y, Hao K, Liu Z, Hui G, Sun T. Bioinformatics Analysis of the Panax ginseng Cyclophilin Gene and Its Anti-Phytophthora cactorum Activity. Plants. 2024; 13(19):2731. https://doi.org/10.3390/plants13192731
Chicago/Turabian StyleZhao, Yu, Jiahong Lu, Yuming Wang, Kaiwen Hao, Zhimei Liu, Ge Hui, and Tianxia Sun. 2024. "Bioinformatics Analysis of the Panax ginseng Cyclophilin Gene and Its Anti-Phytophthora cactorum Activity" Plants 13, no. 19: 2731. https://doi.org/10.3390/plants13192731
APA StyleZhao, Y., Lu, J., Wang, Y., Hao, K., Liu, Z., Hui, G., & Sun, T. (2024). Bioinformatics Analysis of the Panax ginseng Cyclophilin Gene and Its Anti-Phytophthora cactorum Activity. Plants, 13(19), 2731. https://doi.org/10.3390/plants13192731
